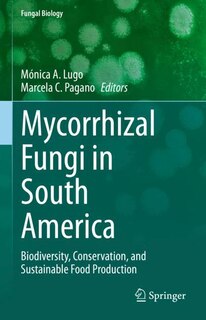

Free Preview of Mycorrhizal Fungi in South America: Biodiversity, Conservation, and Sustainable Food Production
$291.95
Online pricing. Prices and offers may vary in store.

Ship to me
Checking availability…
Buy now & pick up in store
Checking availability…
Find it in store
Checking availability…
Overview
Publisher: Springer Nature
Shipping dimensions: 9" H x 6" W x 1" L
ISBN: 9783031129933
Life stage: null
Ratings & Reviews
Others Also Bought
Mycorrhizal Fungi in South America: Biodiversity, Conservation, and Sustainable Food Production
/en-ca/mycorrhizal-fungi-in-south-america-biodiversity-conservation-and-sustainable-food-production/2D64017E-149A-4DA7-88C1-176E5E7FD4CC.html
2D64017E-149A-4DA7-88C1-176E5E7FD4CC
Mycorrhizal Fungi in South America: Biodiversity, Conservation, and Sustainable Food Production
https://dynamic.indigoimages.ca/v1/books/books/3031129938/1.jpg
291.95
Mycorrhizal Fungi in South America: Biodiversity, Conservation, and Sustainable Food Production
https://dynamic.indigoimages.ca/v1/https://cdn.kobo.com/book-images/65cd17e0-0a6c-45ed-a6a5-b4251a853277/300/300/False/image.jpg
172.1